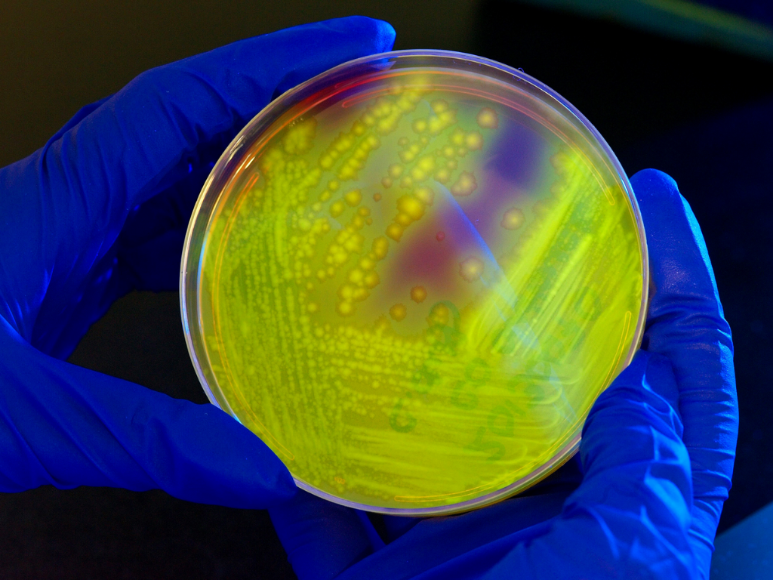
¿Por qué las superbacterias son la nueva gran amenaza?

¿Por qué las superbacterias son la nueva gran amenaza?
-

The Lancet dio a conocer este 2022 una cifra aterradora de fallecimientos a causa de este tipo de bacterias. Conozca aquí más detalles del estudio.
08/04/2022 - 00:001 / 16 -

Se llama superbacterias a las bacterias que han desarrollado una resistencia a los antibióticos que hacen imposible un tratamiento médico convencional.
08/04/2022 - 00:002 / 16 -

Según la investigación publicada en The Lancet en enero de 2022, ya mueren en el mundo anualmente 1’2 millones de personas a causa de las superbacterias. Más que por VIH o malaria.
08/04/2022 - 00:003 / 16 -

Desde que el doctor Fleming descubriera la penicilina en 1928, los antibióticos han sido un arma fundamental para salvar vidas. Pero el abuso de antibióticos ha causado un grave problema: las bacterias han aprendido a eludir su efecto.
08/04/2022 - 00:004 / 16 -

Se trata de una verdadera pesadilla. Si no puede detenerse una infección bacteriana mediante un antibiótico, ¿qué puede hacerse? A veces, aunque suene horrible, se recurre a amputar zonas infectadas.
08/04/2022 - 00:005 / 16 -

El estudio de The Lancet llega a calcular que, si la progresión de las superbacterias continúa, en 30 años estos microbios superpoderosos podrían provocar la muerte de 10 millones de personas cada año.
08/04/2022 - 00:006 / 16 -

El covid ha matado a algo más de cinco millones de seres humanos (en dos años de pandemia), al hablar de 10 millones de muertes por superbacterias podemos apreciar el grado de peligro al que nos exponemos.
08/04/2022 - 00:007 / 16 -

Los científicos coinciden que durante demasiado tiempo las sociedades desarrolladas se hipermedicaron con antibióticos y ello provocó un aprendizaje de las bacterias para defenderse.
08/04/2022 - 00:008 / 16 -

También se ha tratado con antibióticos de modo masivo a los animales de la ganadería industrial. En varios países el uso en animales es restringidos debido a esto.
08/04/2022 - 00:009 / 16 -

Las superbacterias tienen en estado de alerta a la comunidad científica. No hay un modo general de combatirlas.
08/04/2022 - 00:0010 / 16 -

Existen vacunas que protegen de infecciones bacterianas y algún método experimental en el que se lanzan virus a combatir contra las superbacterias.
08/04/2022 - 00:0011 / 16 -

Uno de los tratamientos exitosos contra las superbacterias se aplicó a la belga Karen Northshield. Esta mujer resultó herida en un atentado perpetrado con bomba en Bruselas.
08/04/2022 - 00:0012 / 16 -

Era 2021 y su recuperación se vio truncada por la aparición en su cuerpo de una bacteria resistente al antibiótico. Hubo que extirpar áreas de su cuerpo para salvar su vida. Hasta que llegó la solución.
08/04/2022 - 00:0013 / 16 -

Con Karen Northshield se aplicó una técnica que, según explica Kevin Doxzen (de la Universidad de Arizona) en The Conversation, consiste en recurrir a unos virus denominados “bacteriófagos, también conocidos como fagos, que sobreviven infectando la bacteria, replicándose y saliendo de su huésped, con lo que destruyen la bacteria”.
08/04/2022 - 00:0014 / 16 -

A veces estos microorganismos devoradores de bacterias sólo logran debilitarlas y necesitan la ayuda del antibiótico tradicional.
08/04/2022 - 00:0015 / 16 -

Estas líneas de investigación contra las superbacterias son importantes ya que, según resumió The New York Times en un titular estamos ante “Revenge of the Bacteria: Why We’re Losing the War” (“la venganza de las bacterias: por qué estamos perdiendo la guerra”). Los tratamientos con bacteriófagos son actualmente de carácter experimental.
08/04/2022 - 00:0016 / 16